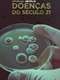
Afflicted

Home › Web Series › Afflicted
Show |
Sickness | Medical
Baffling symptoms. Controversial diagnoses. Costly treatments. Seven people with chronic illnesses search for answers -- and relief.
Disclaimer: All content and media belong to original content streaming platforms/owners like Netflix, Disney+ Hotstar, Amazon Prime Videos, JioCinema, SonyLIV etc. 91mobiles entertainment does not claim any rights to the content and only aggregate the content along with the service providers links.
Baffling symptoms. Controversial diagnoses. Costly treatments. Seven people with chronic illnesses search for answers -- and relief.
In 2019, four cast members with chronic illnesses filed a lawsuit against Netflix and show producers for defamation for portraying them as "lazy, crazy, hypochondriacs and/or malingerers."















